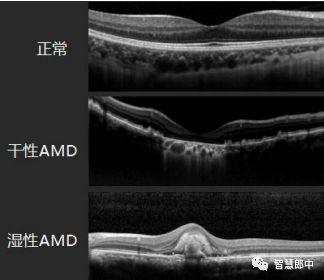
年龄相关性黄斑变性辅助检查,年龄相关性黄斑变性

智慧郎中2020-04-23 07:53
一、概述
年龄相关性黄斑变性病是由于黄斑部视网膜色素上皮细胞和视网膜退行性变而引起的不可逆性的中心视力下降或丧失。

正常眼底视网膜(右眼)
在我国70 岁以上发病率高达 15.5%,是50 岁以上老年人首要致盲性眼病。分为干性和湿性两种类型,其中干性约占80%~ 85%,通常进展缓慢,湿性有新生血管异常的15%~20%,进展迅速,导致严重的中心视力丧失,严重者可导致失明。
正常黄斑、干性黄斑变性、湿性黄斑变性的OCT检查图
1. 萎缩型黄斑变性:又称干性黄斑变性,非渗出性黄斑变性,无新生血管异常的黄斑变性,约占所有黄斑变性的 80%~ 85%,通常进展缓慢。

干性黄斑变性眼底照片(左眼)

干性黄斑变性的眼底血管造影(右眼) (左眼)
2. 渗出型黄斑变性:湿性黄斑变性,有新生血管异常的黄斑变性,约占黄斑变性患者的 15%~20%,与干性相 比,湿性进展得更为迅速,而且导致更严重的中心视力丧失,严重者可导致失明。

湿性黄斑变性眼底照片(右眼)

湿性黄斑变性眼底血管造影(右眼)
二、年龄相关性黄斑变性临床表现
1. 中心视力下降。 2.视野中心有黑影遮挡。3.视物变形、直线变弯、水平线变波浪形等。4.对比度会下降,世界变成灰蒙蒙。5.立体视觉功能下降。6.色觉功能减退。

三、年龄相关性黄斑变性治疗
一)西医治疗:
1. 干性黄斑变性,病程长进展缓慢,无特效治疗方法,主要是去除诱因,无戒烟,也可以补充多种抗氧化维生素和微量元素锌治疗。
2. 湿性黄斑变性,
1)首先璃体内注射血管内皮生长因子*制剂抑**(贝伐珠单抗、雷珠单抗或阿柏西普),不良反应是价格昂贵,反复注射,长期应用疗效降低,已经严重并发症;
2)光动力疗法,副作用是易复发,而且视力下降会更严重。
3)以及补充锌和抗氧化维生素。

玻璃体内注射
二)中医中医治疗:年龄相关性黄斑变性是中医眼科优势病种,中医中药针灸辨证治疗具有良好的疗效。
主要分型为:
精气亏虚证 方药:五子衍宗丸合四物汤或杞菊地黄丸
气液失调证 方药:小柴胡汤合当归芍药散加减
络伤血溢证 方药:生蒲黄汤加减
痰瘀互结证 方药:化坚二陈汤合升降散加减
主要针刺穴位:
近端辨证取穴:精明、攒竹、眉冲、承泣、四白、瞳子髎、阳白、目窗、头临泣、丝竹空、角孙、球后、太阳等
远端取穴:14经脉随症选取。
